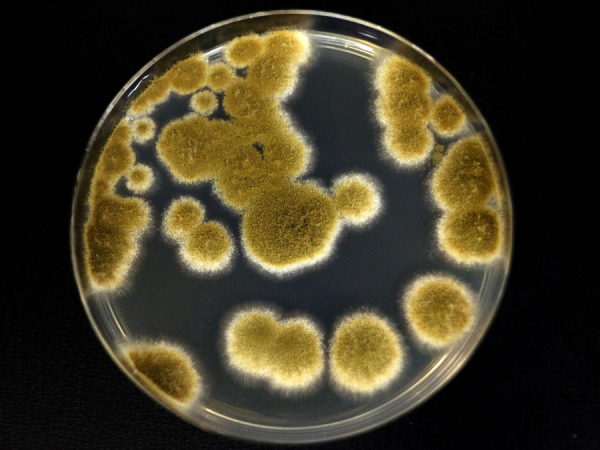
Funghi Marte

Resistenza fungina agli stress extraterrestri: verso la colonizzazione biologica di Marte
Un fungo resiliente potrebbe sopravvivere su Marte e nello spazio grazie alla sua capacità di entrare in stato dormiente, resistere alle radiazioni e adattarsi a condizioni estreme, offrendo spunti per…
Continua a leggereGuarda la Terra fotografata da oltre 6 miliardi di chilometri: la foto reale
La Pale Blue Dot rappresenta una delle foto più famose della nostra Terra, un puntino perso nell’oscurità. Ecco la foto storica Advertisement La Pale Blue Dot è una fotografia del pianeta Terra scattata il…
Continua a leggereScoperto un enorme serbatoio invisibile di magma sotto la Toscana
Un team internazionale guidato dall’Università di Ginevra ha individuato nel sottosuolo di Larderello e del Monte Amiata due enormi serbatoi di roccia parzialmente fusa, per un volume complessivo di circa…
Continua a leggereIl sole ha “urlato” a marzo e qualcuno l’ha registrato (VIDEO)
Il 18 marzo 2026 l’astrofilo DudeLovesSpace ha ripreso un brillamento di classe M2.7 sulla macchia solare AR4392. Le onde radio dell’esplosione del Sole sono state trasformate in suono Advertisement La…
Continua a leggereMarte, scoperta incredibile: Curiosity individua rocce dall’aspetto “draconico”
Il rover Curiosity della NASA scopre su Marte misteriose rocce simili a scaglie di drago: una scoperta sorprendente che entusiasma gli scienziati e potrebbe svelare nuovi segreti sul passato del…
Continua a leggereE se tutto fosse nato da buchi neri esplosi? La teoria che riscrive l’universo
I buchi neri primordiali esplosivi potrebbero aver plasmato l’universo primordiale, contribuendo alla formazione della materia e influenzando l’evoluzione cosmica come la conosciamo oggi. Advertisement Nelle primissime fasi successive al Big…
Continua a leggereL’Interstellar di Spielberg era pieno di alieni e robot (poi arrivò Nolan)
Nel 2006 Steven Spielberg si innamorò di un’idea dell’astrofisico Kip Thorne. Lavorò alla sceneggiatura di Interstellar per un anno, poi lasciò. Il film lo fece Christopher Nolan, che stravolse ogni…
Continua a leggereInnalzamento dei mari: pubblicate mappe molto inquietanti fino al 2150
Grazie a una mappa interattiva, è ora possibile esplorare gli effetti del cambiamento del livello dei mari a livello globale. Gli scenari previsti suscitano preoccupazione Advertisement Il Sea Level Change Team della…
Continua a leggereE se il tempo scorresse in tanti modi diversi in uno stesso momento?
Nessuno sa davvero come funzioni, ma il tempo potrebbe essere ancora più complesso di quello che sembra: una sovrapposizione di stati diversi in uno stesso momento, in accordo con i…
Continua a leggerePerché i buchi neri supermassicci crescono così lentamente?
Una nuova ricerca ha scoperto le cause per cui, dopo il Mezzogiorno Cosmico, i buchi neri supermassicci hanno rallentato la loro crescita. Advertisement Grazie ai nostri potenti telescopi a infrarossi,…
Continua a leggere








